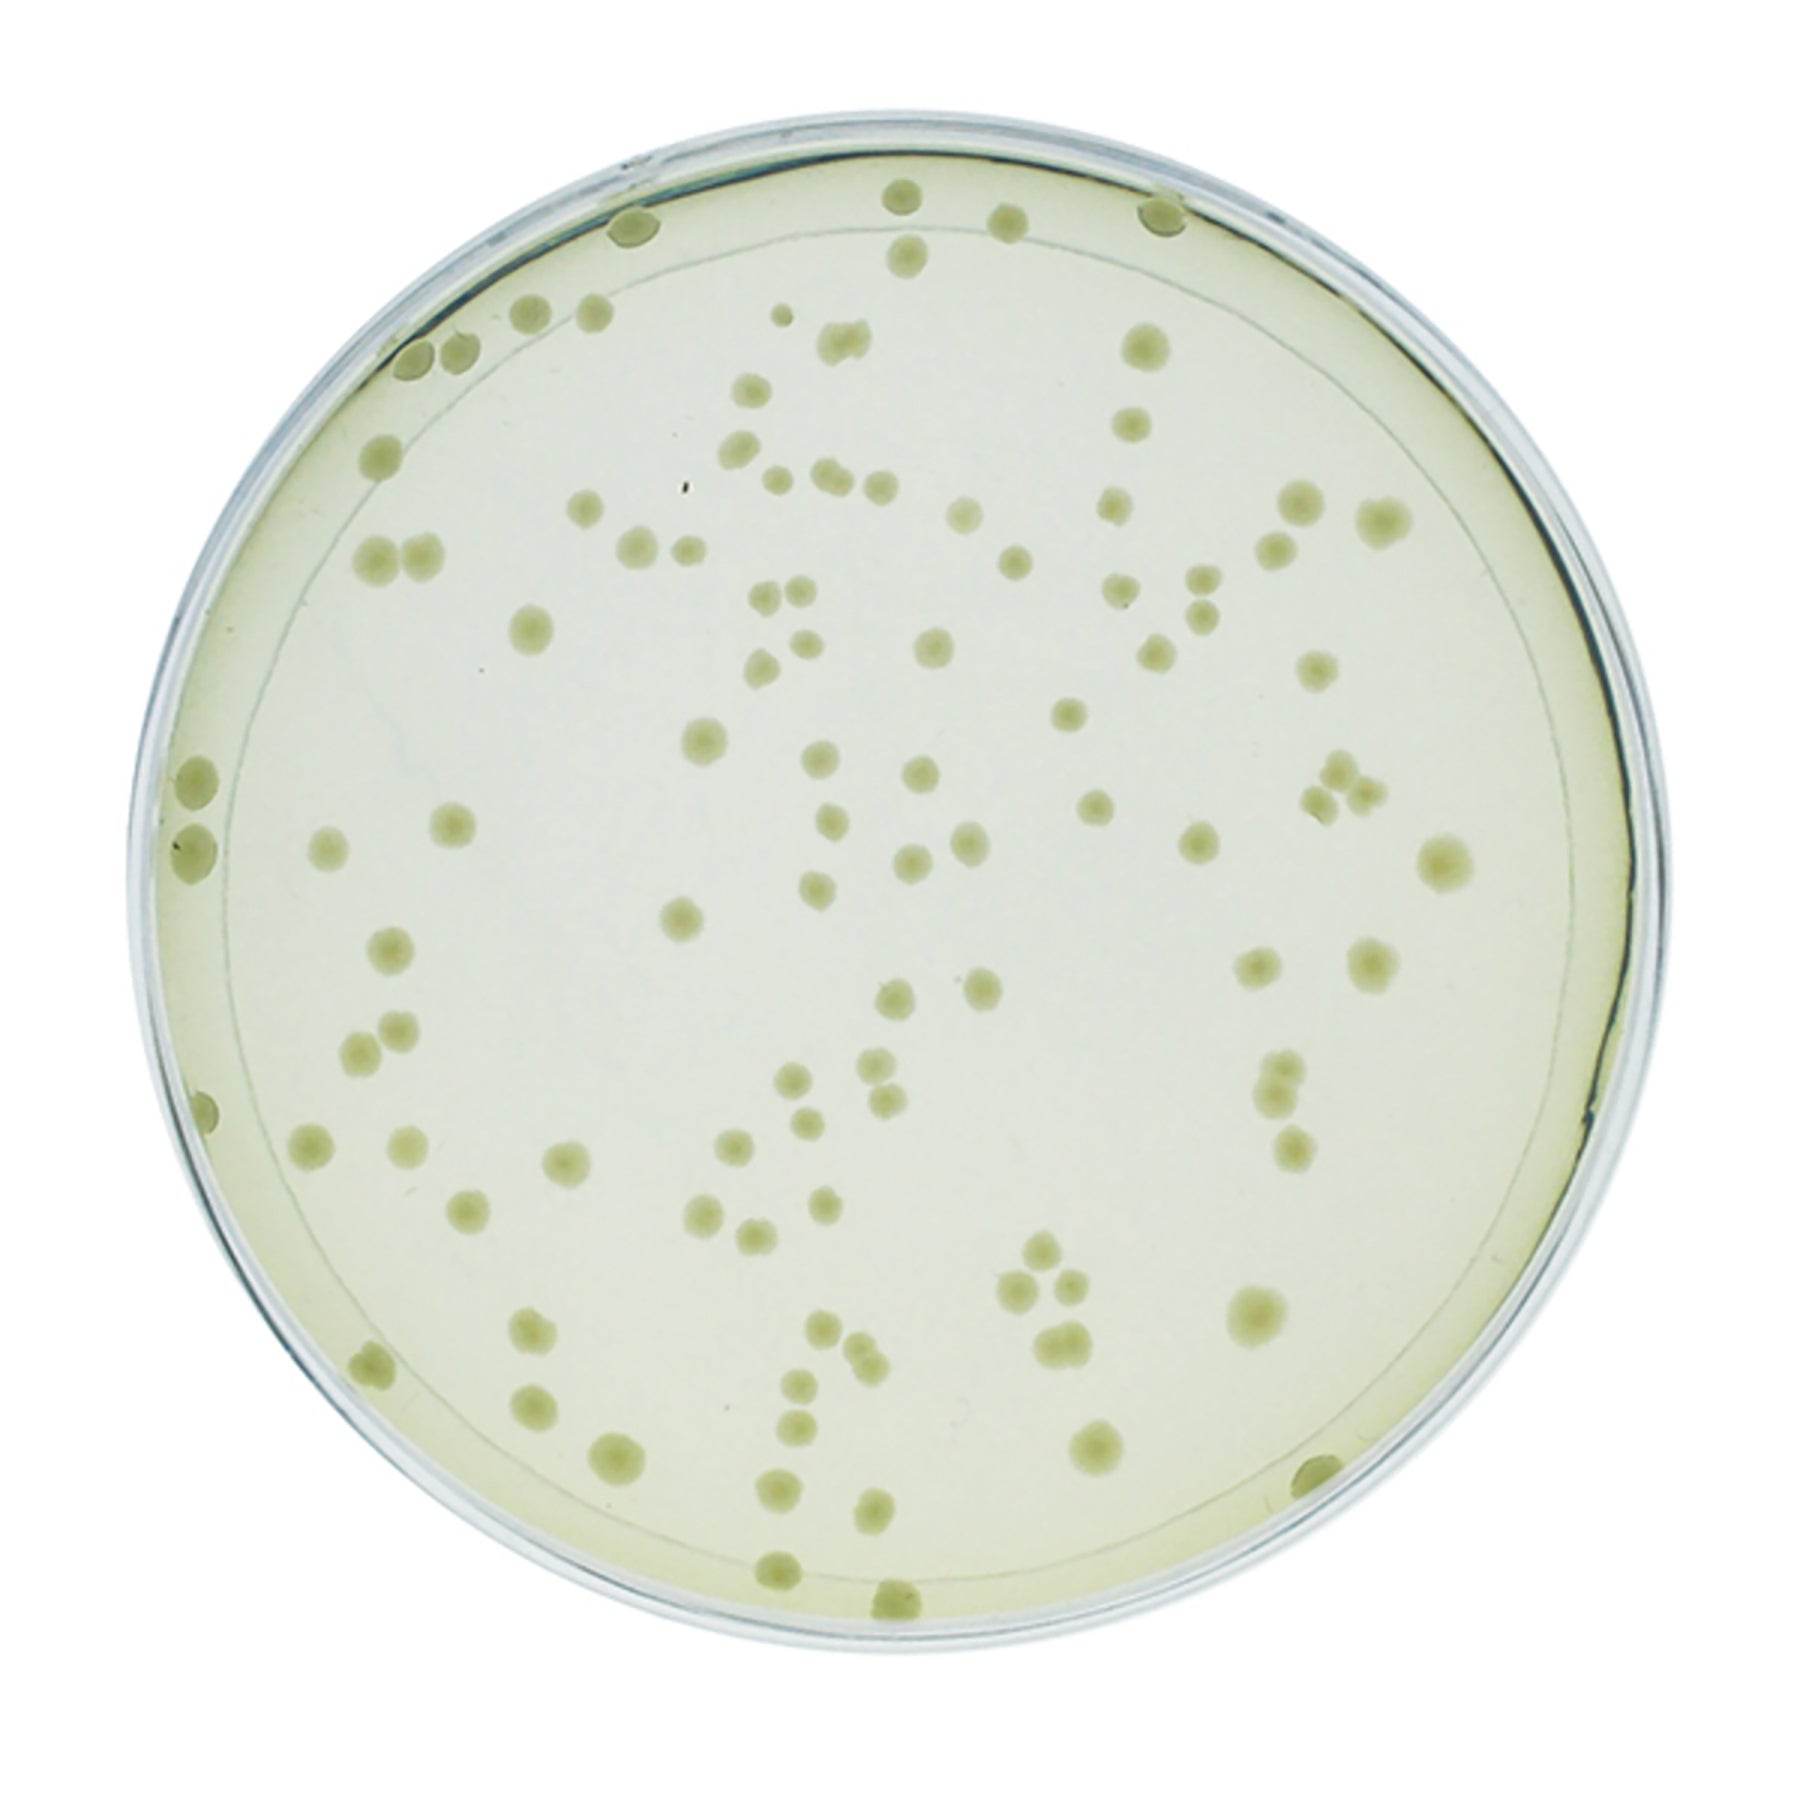

All Products
Showing 121 - 144 of 1448 products
Display
View

EDVOTEK
Exploring the Genetics of Taste: SNP Analysis of the PTC Gene Using PCR
Sale price$277.00 CAD
Filters (0)